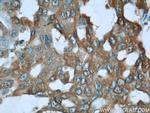
ALDOA Antibody in Immunohistochemistry (Paraffin) (IHC (P))

Search
Proteintech
ALDOA Polyclonal Antibody
{{$productOrderCtrl.translations['antibody.pdp.commerceCard.promotion.promotions']}}
{{$productOrderCtrl.translations['antibody.pdp.commerceCard.promotion.viewpromo']}}
{{$productOrderCtrl.translations['antibody.pdp.commerceCard.promotion.promocode']}}: {{promo.promoCode}} {{promo.promoTitle}} {{promo.promoDescription}}. {{$productOrderCtrl.translations['antibody.pdp.commerceCard.promotion.learnmore']}}
产品信息
11217-1-AP
种属反应
已发表种属
宿主/亚型
分类
类型
抗原
偶联物
形式
浓度
规格
纯化类型
保存液
内含物
保存条件
运输条件
产品详细信息
Immunogen sequence: PYQYPALTP EQKKELSDIA HRIVAPGKGI LAADESTGSI AKRLQSIGTE NTEENRRFYR QLLLTADDRV NPCIGGVILF HETLYQKADD GRPFPQVIKS KGGVVGIKVD KGVVPLAGTN GETTTQGLDG LSERCAQYKK DGADFAKWRC VLKIGEHTPS ALAIMENANV LARYASICQQ NGIVPIVEPE ILPDGDHDLK RCQYVTEKVL AAVYKALSDH HIYLEGTLLK PNMVTPGHAC TQKFSHEEIA MATVTALRRT VPPAVTGITF LSGGQSEEEA SINLNAINKC PLLKPWALTF SYGRALQASA LKAWGGKKEN LKAAQEEYVK RALANSLACQ GKYTPSGQAG AAASESLFVS NHAY (2-364 aa encoded by BC016800)
靶标信息
Aldolase encodes a member of the class I fructose-bisphosphate aldolase protein family. The encoded protein is a glycolytic enzyme that catalyzes the reversible conversion of fructose-1,6-bisphosphate to glyceraldehyde 3-phosphate and dihydroxyacetone phosphate. Three aldolase isozymes (A, B, and C), encoded by three different genes, are differentially expressed during development. Mutations in this gene have been associated with Glycogen Storage Disease XII, an autosomal recessive disorder associated with hemolytic anemia. Disruption of this gene also plays a role in the progression of multiple types of cancers. Related pseudogenes have been identified on chromosomes 3 and 10.
仅用于科研。不用于诊断过程。未经明确授权不得转售。
生物信息学
蛋白别名: ALDOA; Aldolase 1; aldolase 1, A isoform; aldolase A (EC 4.1.3.13); aldolase A, fructose-bisphosphate; epididymis secretory sperm binding protein Li 87p; fructose 1,6-diphosphate aldolase A (EC 4.1.2.13); fructose-1,6-bisphosphate triosephosphate-lyase; Fructose-bisphosphate aldolase A; Lung cancer antigen NY-LU-1; Muscle-type aldolase; unnamed protein product
基因别名: ALDA; Aldo-1; Aldo1; ALDOA; GSD12; HEL-S-87p; RNALDOG5
UniProt ID: (Human) P04075, (Mouse) P05064, (Rat) P05065
Entrez Gene ID: (Human) 226, (Mouse) 11674, (Rat) 24189